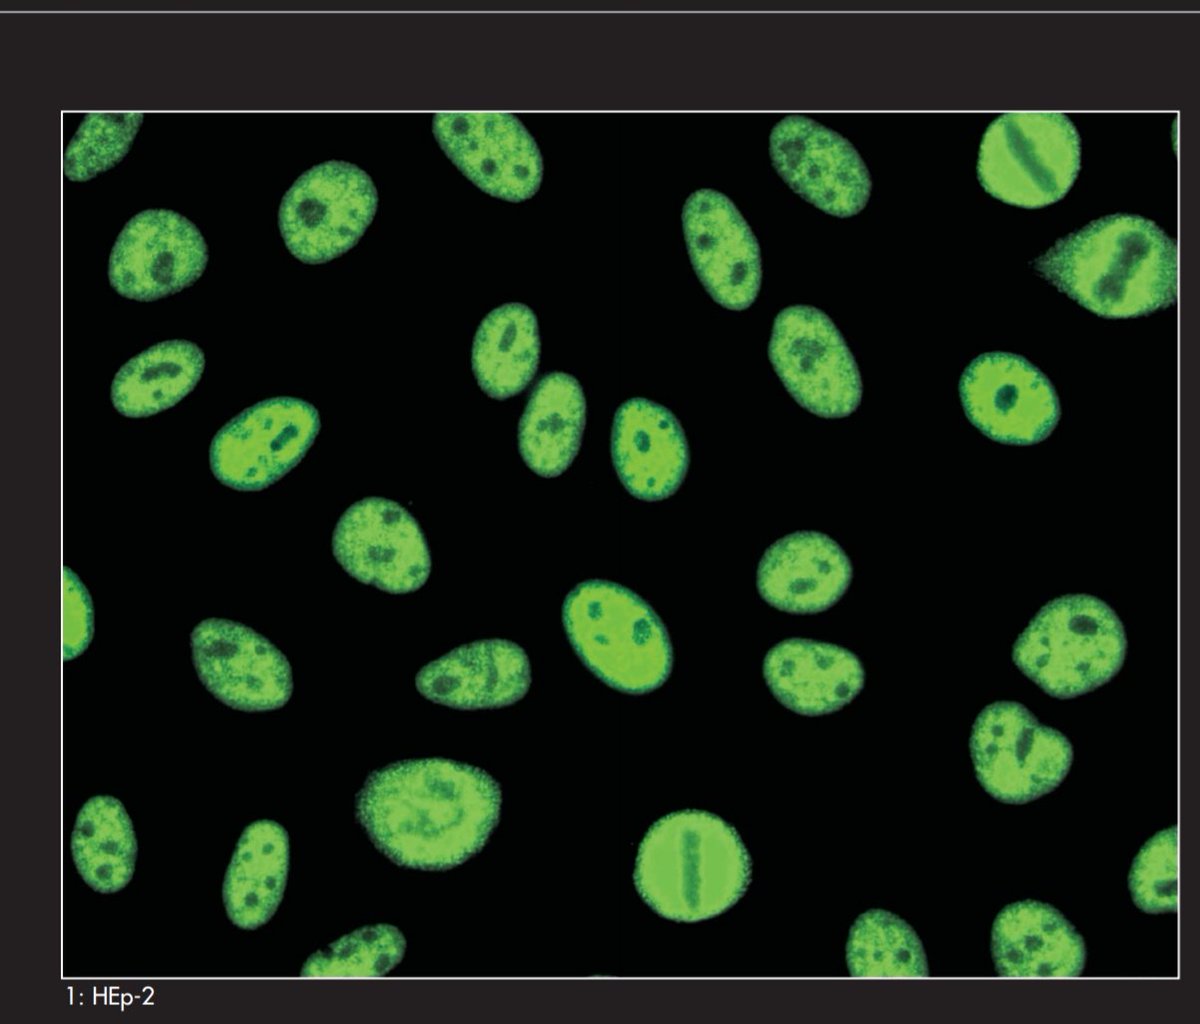
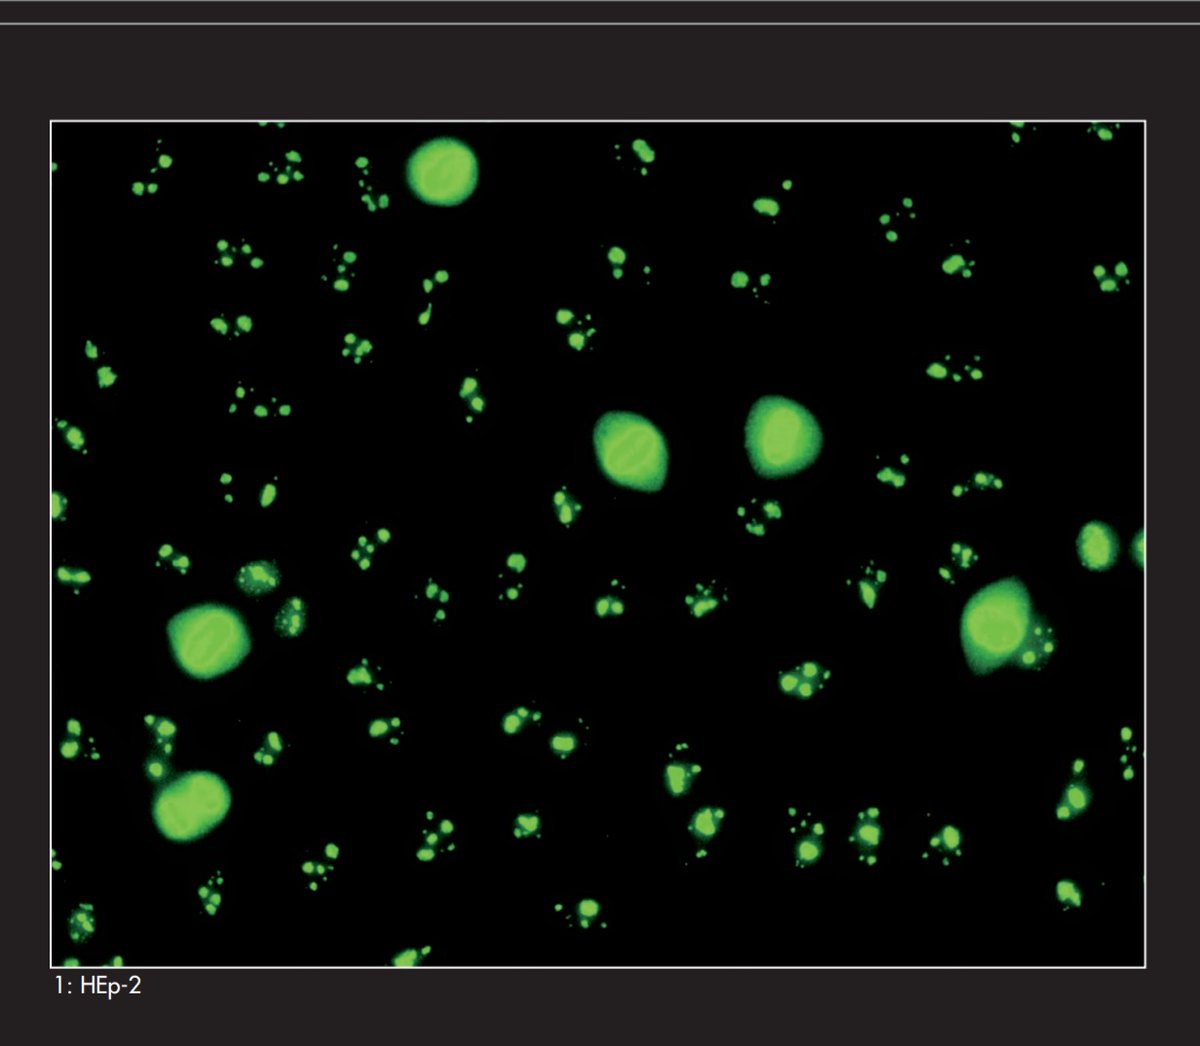

في هذا الثريد بتكلم عن
#Antinuclear_antibodies_test
#patterns_of_ANA
من أهم فحوصات لتشخيص الامراض المناعية
ويمكن الأغلبية درس عنها نظري بالجامعة ويتخرج وما يشتغلها
بعد هذا الثريد بتكون قادر على تتميز انواعpatterns واهم الامراض المرتبطة بكل نوع
بشكل مبسط 🔬
#Autoimmune_disease
#Antinuclear_antibodies_test
#patterns_of_ANA
من أهم فحوصات لتشخيص الامراض المناعية
ويمكن الأغلبية درس عنها نظري بالجامعة ويتخرج وما يشتغلها
بعد هذا الثريد بتكون قادر على تتميز انواعpatterns واهم الامراض المرتبطة بكل نوع
بشكل مبسط 🔬
#Autoimmune_disease
نبدا بأول نوع من patterns
1-#Homogeneous_pattern
وهو مرتبط بتشخيص مرض
Systemic lupus erythematosus (#SLE)
Antibodies against ssDNA/dsDNA and histone antigens
نلاحظ في هذا النوع خليه مصبوغه بالكامل مع وجود Chromosome مضبوغ في Metaphase وهي المؤشر عليها بالسهم في الصورة
1-#Homogeneous_pattern
وهو مرتبط بتشخيص مرض
Systemic lupus erythematosus (#SLE)
Antibodies against ssDNA/dsDNA and histone antigens
نلاحظ في هذا النوع خليه مصبوغه بالكامل مع وجود Chromosome مضبوغ في Metaphase وهي المؤشر عليها بالسهم في الصورة
2- #Speckeld_pattern
وهو مرتبط بتشخيص Sjogren's syndrome , SLE and mixed connective tissue disorders (#MCTD)
Antibodies to Sm, RNP, SS-A/SS-B, PM-1, and PCNA antigen
نلاحظ في هذا النوع وجود ثقوب داخل النواة وقد تكون Fine or coarse
وعدم وجود Chromosome في Metaphase
وهو مرتبط بتشخيص Sjogren's syndrome , SLE and mixed connective tissue disorders (#MCTD)
Antibodies to Sm, RNP, SS-A/SS-B, PM-1, and PCNA antigen
نلاحظ في هذا النوع وجود ثقوب داخل النواة وقد تكون Fine or coarse
وعدم وجود Chromosome في Metaphase
3- #Nuleolar_pattern
وهو مرتبط بتشخيص Systemic sclerosis (SS)
And some cases of SLE
ونلاحظ صبغة النوية داخل النواة مع وجود Chromosome في Metaphase
وهو مرتبط بتشخيص Systemic sclerosis (SS)
And some cases of SLE
ونلاحظ صبغة النوية داخل النواة مع وجود Chromosome في Metaphase
4- #centromere_pattern
وهو مرتبط بتشخيص مرض CREST
ونلاحظ وجود نقاط صغيرة ممتدة على النواة وتصل عددها الى ٩٠ نقطة مع وجود Chromosome في مرحلة Metaphase and Telophase
وهو مرتبط بتشخيص مرض CREST
ونلاحظ وجود نقاط صغيرة ممتدة على النواة وتصل عددها الى ٩٠ نقطة مع وجود Chromosome في مرحلة Metaphase and Telophase
بهذا يكون خلصت هذا الثريد البسيط والمهم للي مهتمين بقسم #المناعة 🔬 ويوجد انواع patterns اخرى تندرج تحت كل نوع ما حبيت اذكرها عشان لا تتلخبط المعلومات لان مهم تثبت الانوع الاساسيه وبعدين ممكن نتوسع ونذكر الأنواع الأخرى
واتمنى تكون هذه المعلومات مفيدة 🌸
واتمنى تكون هذه المعلومات مفيدة 🌸
Loading suggestions...